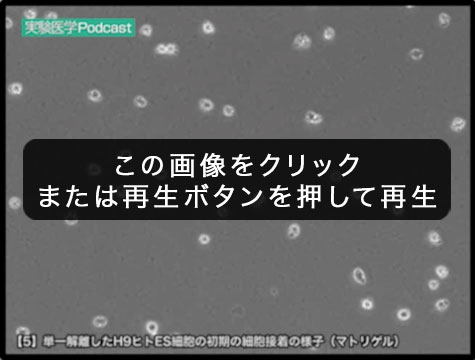
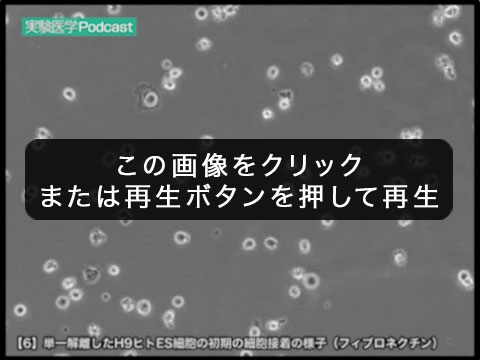
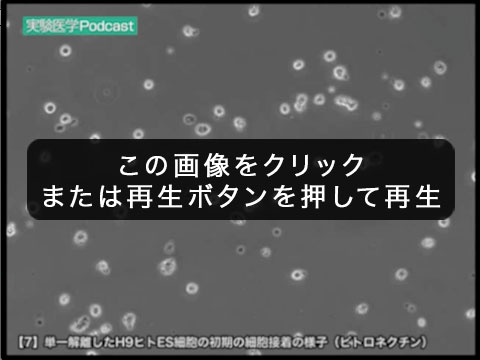

骨代謝ー「見えざる手」が制御する骨破壊と骨形成
リウマチ・骨粗鬆症の発症機構と分子標的治療
- 2013年03月19日発行
- B5判
- 129ページ
- ISBN 978-4-7581-0094-6
- 2,200円(本体2,000円+税)
- 在庫:なし
近年の細胞生物学および分子生物学の進歩によって,骨組織を構成する骨芽細胞,破骨細胞,骨細胞などの分化・活性化に関与する成長因子や転写因子,そして細胞内シグナル伝達機構が詳細に明らかにされてきた.しかし各演奏者がばらばらに演奏していたのではオーケストラが成り立たないように,骨組織が全体としての調和を保つためには個々の細胞を制御する上位の制御機構が存在することが必要である.骨組織というオーケストラがすばらしい演奏を行うためにはすばらしい指揮者が存在するはずである.本特集ではこのような視点にたって,骨代謝を制御する「見えざる手」解明の手がかりとなるようなトピックスをとり上げた.
生体で新陳代謝され続ける骨の謎に迫る! ビタミンD・小胞体ストレスの作用からin vivoイメージング・数理モデリングまで,リウマチ・骨粗鬆症の分子標的治療へ向けた統合的アプローチを紹介.
特集
リウマチ・骨粗鬆症の発症機構と分子標的治療
トピックス
連載
関連情報
特集/カレントトピックス Online Supplemental Data
![[1]](/jikkenigaku/images/washu_number_1.gif) in vivoイメージングによる成熟破骨細胞の可視化
in vivoイメージングによる成熟破骨細胞の可視化- 菊田順一/石井 優
- ※ 865ページ参照
- 6秒 2013年3月19日公開
- 説明:成熟破骨細胞をGFPで標識したマウス(a3-GFPマウス)の骨髄腔を生体2光子励起顕微鏡で観察した.骨表面で骨吸収を行っている成熟破骨細胞には,「骨表面で止まっていて骨吸収をしている細胞」と「骨表面を移動していて骨吸収を行っていない細胞」の少なくとも2種類が存在する.

- ※本動画の著作権者および株式会社羊土社の許可なく複製,公衆送信,修正・変更,商業的に利用したり,第三者のウェブサイトに掲示・転載することは,著作権の侵害とみなされますのでご遠慮下さい
- ※通信環境やご利用のブラウザの種類などのアクセス環境によっては動画が乱れることがあります.予めご了承ください
本書中に掲載された広告をご紹介します.より詳細な資料を希望される方は,こちらのページから資料請求いただくことができますので,該当企業にチェックを付け,下記の「資料請求する」をクリックして,資料の送付先をご入力ください.
掲載広告一覧・資料請求
| 広告代理店 |
|---|
| 株式会社エー・イー企画 |
| 101-0003 東京都千代田区一ツ橋2-4-4 岩波書店一ツ橋別館4F |
| TEL 03(3230)2744(代表)/ FAX 03(3230)2479 |
| E-mail:adinfo@aeplan.co.jp URL:http://www.aeplan.co.jp/ |
購入方法・送料について
本書は全国の羊土社取扱書店にてご購入いただけます.店頭にて見当たらない場合は,下記情報を書店にお伝え下さい.
- 【本書名】実験医学:骨代謝ー「見えざる手」が制御する骨破壊と骨形成〜リウマチ・骨粗鬆症の発症機構と分子標的治療
- 【出版社名】羊土社
お近くに取扱書店が無い場合,特に海外でご覧になりたい場合,羊土社HPでのご注文および発送も承っておりますので,下記ご参照のうえ,注文をご検討ください.
羊土社HPでのご注文について
本書を羊土社HPにてご購入いただきますと,本体価格に加えて,送付先・お支払い方法などにより下記の費用がかかります.お手続き等詳細は書籍購入案内のページをご参照ください.
| 分類 | 項目 | 費用 | |
|---|---|---|---|
| 国内 | 消費税 | +200円 | |
| 送料 | +500円 | ||
| 手数料(代引きのみ) | +300円 | ||
| 海外 | 航空便送料 | 第1地帯(アジア、グアム、ミッドウェイ等) | +680円 |
| 第2地帯(オセアニア、中近東、北米、中米) | +870円 | ||
| 第2地帯(ヨーロッパ) | +870円 | ||
| 第3地帯(アフリカ、南米) | +1130円 | ||
| EMS便送料 | 第1地帯(アジア、グアム、ミッドウェイ等) | +1400円 | |
| 第2地帯(オセアニア、中近東、北米、中米) | +2000円 | ||
| 第2地帯(ヨーロッパ) | +2200円 | ||
| 第3地帯(アフリカ、南米) | +2400円 | ||
※この表は本書のみご購入いただいた場合の費用をまとめたものです.他の書籍を同時に購入する場合はお申し込み金額や重量により費用が異なってまいりますのでご注意ください.
海外からのご注文は、日本郵便株式会社の国際郵便取扱の状況を鑑みて、現在発送を原則停止しております。
(2021年8月23日)
法人向け 購入のお問い合わせ
法人での書籍の一括購入につきまして,「見積書や請求書払い」「複数の発送先への対応」「研修用などで使用する書籍の選定についてのアドバイス」等、下記フォームよりお気軽にお問い合わせください。